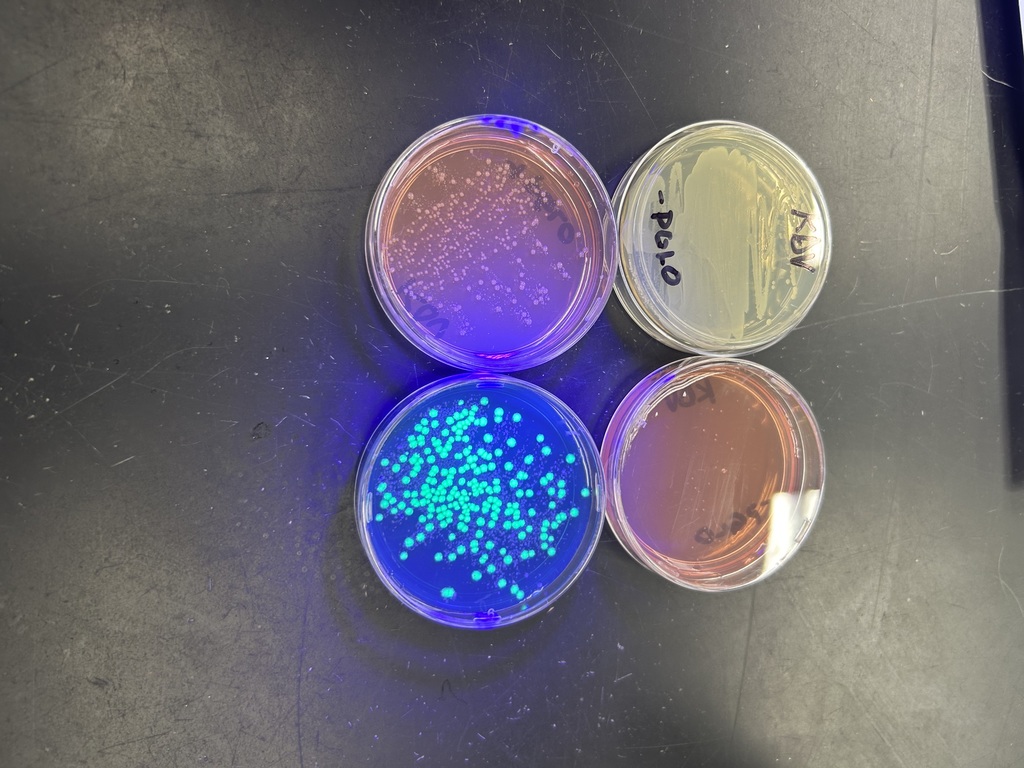
Results of a biotechnology lab students conducted in biology class.

🌱 🌿 🍃 SAVE THE DATE! 🌾 🌸 🌼
The spring preview we recently enjoyed got many gardeners in our community ready to start planting. Keep that excitement going, because we are less than a month away from the Powhatan High School Annual Spring Plant Sale. The window is shorter this year, so plan ahead. The sale will be held at the PHS Greenhouse from 8 a.m. to 5 p.m. on Thursday, April 16 and Friday April 17, and from 9 a.m. to noon on Saturday, April 18. Take Judes Ferry Road to Old Church Road. Turn by the tennis courts and follow the road to the greenhouse behind the school. Cash or Check only. The plant list is coming soon. For questions, contact emilee.meinhard@powhatan.k12.va.us.
All sales benefit the PHS FFA and Horticulture programs. Horticulture Science and Greenhouse Production Management students do a fantastic job growing the plants for the sale, as you can see in these photos.
#WeArePCPS #TeamPowhatan
The spring preview we recently enjoyed got many gardeners in our community ready to start planting. Keep that excitement going, because we are less than a month away from the Powhatan High School Annual Spring Plant Sale. The window is shorter this year, so plan ahead. The sale will be held at the PHS Greenhouse from 8 a.m. to 5 p.m. on Thursday, April 16 and Friday April 17, and from 9 a.m. to noon on Saturday, April 18. Take Judes Ferry Road to Old Church Road. Turn by the tennis courts and follow the road to the greenhouse behind the school. Cash or Check only. The plant list is coming soon. For questions, contact emilee.meinhard@powhatan.k12.va.us.
All sales benefit the PHS FFA and Horticulture programs. Horticulture Science and Greenhouse Production Management students do a fantastic job growing the plants for the sale, as you can see in these photos.
#WeArePCPS #TeamPowhatan










Eighth graders in Mr. Raychouni’s Intro to Game Design & Robotics classes at Powhatan Middle School were recently joined by AP Computer Science students from Powhatan High School, who stepped into the role of “student teachers.” 💻 Over two days, Mr. Wilson brought his high schoolers to offer lessons exploring game development while serving as coding coaches . The initiative, supported in partnership with Mr. Acevedo, gave younger students a glimpse into future coursework and career pathways they can take when they reach high school. 🧡🖤
#WeArePCPS #TeamPowhatan
#WeArePCPS #TeamPowhatan










In Mrs. Vallent’s AP Biology class at Powhatan High School, students are getting hands-on with biotechnology by using the same types of techniques found in research labs, law enforcement, and industry.
They conducted a gel electrophoresis lab where they made agarose gels and submerged them in a conductive buffer solution that is hooked up to a power source, resulting in the proteins separating by their size and charge.
They also conducted a bacterial transformation lab, introducing a small piece of DNA (a plasmid) into E. coli bacteria. This plasmid included instructions to produce a glowing protein originally found in jellyfish, resulting in visible, glowing bacteria in their lab samples. Impressively, every student successfully saw their transformation results! 🧡🖤
#WeArePCPS #TeamPowhatan
They conducted a gel electrophoresis lab where they made agarose gels and submerged them in a conductive buffer solution that is hooked up to a power source, resulting in the proteins separating by their size and charge.
They also conducted a bacterial transformation lab, introducing a small piece of DNA (a plasmid) into E. coli bacteria. This plasmid included instructions to produce a glowing protein originally found in jellyfish, resulting in visible, glowing bacteria in their lab samples. Impressively, every student successfully saw their transformation results! 🧡🖤
#WeArePCPS #TeamPowhatan

🎸 Rockin’ With Dolly is almost here! 🚚
On March 21 from 7:00 a.m. to 1:00 p.m., swing by Luck Stone in Powhatan and fill your pickup or single axle trailer for just $20 – all while supporting the Powhatan Education Foundation and Powhatan’s Imagination Library.
Choose from 57’s or 21A (perfect for driveways), and don’t forget to bring a tarp for transport.
Great deal, great cause, and a great way to help put books in the hands of our community’s youngest learners. 🧡🖤
#WeArePCPS #TeamPowhatan
On March 21 from 7:00 a.m. to 1:00 p.m., swing by Luck Stone in Powhatan and fill your pickup or single axle trailer for just $20 – all while supporting the Powhatan Education Foundation and Powhatan’s Imagination Library.
Choose from 57’s or 21A (perfect for driveways), and don’t forget to bring a tarp for transport.
Great deal, great cause, and a great way to help put books in the hands of our community’s youngest learners. 🧡🖤
#WeArePCPS #TeamPowhatan

A big thank you to our School Bus Drivers and Transportation Team for safely getting our students to school today. With last night’s storm bringing damage and road closures, your dedication, flexibility, and care for our students truly stood out. 🧡🖤
#WeArePCPS #TeamPowhatan
#WeArePCPS #TeamPowhatan

Due to road closures, several buses will be picking up at alternative locations. An email has been sent to all transportation riders. Please check your email to see if your route is impacted.

All Powhatan County Public Schools will operate on a two-hour delay today, March 17th, due to road closures following last night’s storms. While all schools have power, the delay will allow for improved visibility for safer navigation for our drivers.
We understand this may cause inconvenience for families, and we appreciate your understanding as we prioritize the safety of our school community.
We understand this may cause inconvenience for families, and we appreciate your understanding as we prioritize the safety of our school community.

Powhatan County Public Schools will be closed on Monday, March 16th due to the forecast of severe thunderstorms, including a moderate risk of high winds and enhanced risk tornadoes. Because the timing of the storm system is from late morning into the evening, coinciding with afternoon dismissal and student transportation, the decision has been made out of an abundance of caution to ensure the safety of our students and staff. All evening activities are canceled.
We understand this may cause inconvenience for families, and we appreciate your understanding as we prioritize the safety of our school community.

Check out this lovely photo school bus driver Liz Steigman captured on Thursday while waiting for the end of the school day at Flat Rock Elementary.
#WeArePCPS #TeamPowhatan
#WeArePCPS #TeamPowhatan

REMINDER: Friday, March 13 is a Student Holiday and Teacher Work Day. Monday, March 16 is a Full Instructional Day for Staff and Students.
Additionally, the School Board voted this week to return Monday, April 6 as a Student and Staff Holiday. It was previously reclaimed as a snow make-up day.
#WeArePCPS #TeamPowhatan
Additionally, the School Board voted this week to return Monday, April 6 as a Student and Staff Holiday. It was previously reclaimed as a snow make-up day.
#WeArePCPS #TeamPowhatan

PHS students offer free tax preparation through VITA program
POWHATAN, VA – Powhatan High School accounting students are offering free income tax preparation to qualified individuals and families through the Internal Revenue Service’s Volunteer Income Tax Assistance (VITA) program.
Under the supervision of their teacher, students who earned IRS certification are providing basic tax return preparation for households with an annual income of less than $60,000. This is the high school’s second year offering a hands-on learning opportunity that allows students to apply their accounting knowledge while helping members of the community.
Two tax preparation sessions remain this year. Services will be offered from 9 a.m. to noon on Saturday, March 14, and Saturday, April 11 at Powhatan High School, 1800 Judes Ferry Road.
Walk-ins are welcome, or appointments can be made by calling 434-480-1744.
Individuals planning to use the service should bring Social Security or ITIN cards for all individuals listed on the return, a photo ID for the taxpayer and spouse if filing jointly, income documents such as W-2s or 1099s, and other relevant tax documents. Bringing a copy of last year’s tax return and bank account information for direct deposit is also recommended.
The VITA program has helped provide free tax preparation services to communities for more than 50 years while giving students valuable real-world experience.
POWHATAN, VA – Powhatan High School accounting students are offering free income tax preparation to qualified individuals and families through the Internal Revenue Service’s Volunteer Income Tax Assistance (VITA) program.
Under the supervision of their teacher, students who earned IRS certification are providing basic tax return preparation for households with an annual income of less than $60,000. This is the high school’s second year offering a hands-on learning opportunity that allows students to apply their accounting knowledge while helping members of the community.
Two tax preparation sessions remain this year. Services will be offered from 9 a.m. to noon on Saturday, March 14, and Saturday, April 11 at Powhatan High School, 1800 Judes Ferry Road.
Walk-ins are welcome, or appointments can be made by calling 434-480-1744.
Individuals planning to use the service should bring Social Security or ITIN cards for all individuals listed on the return, a photo ID for the taxpayer and spouse if filing jointly, income documents such as W-2s or 1099s, and other relevant tax documents. Bringing a copy of last year’s tax return and bank account information for direct deposit is also recommended.
The VITA program has helped provide free tax preparation services to communities for more than 50 years while giving students valuable real-world experience.

Good evening PCPS Community. The Powhatan County School Board Recap for this week’s budget workshop is ready to view. As always, the goal of this newsletter is to help people who don't have the time to come to or watch full School Board meetings still stay abreast of what is going on in our school division. The newsletter link is in the comments.

Powhatan County School Board & Board of Supervisors Joint Budget Workshop
Pursuant to Virginia Code § 2.2-3707: Please take notice that the Powhatan County School Board will be in a joint budget workshop with the Board of Supervisors on:
DATE: Wednesday, March 11, 2026
TIME: 3:00 PM
LOCATION: Powhatan Village Building
3910 Old Buckingham Road, Powhatan, VA
This notice is being provided in accordance with the Virginia Freedom of Information Act. This meeting will be open to the public.
Pursuant to Virginia Code § 2.2-3707: Please take notice that the Powhatan County School Board will be in a joint budget workshop with the Board of Supervisors on:
DATE: Wednesday, March 11, 2026
TIME: 3:00 PM
LOCATION: Powhatan Village Building
3910 Old Buckingham Road, Powhatan, VA
This notice is being provided in accordance with the Virginia Freedom of Information Act. This meeting will be open to the public.

Powhatan County School Board Notice of Special Meeting Attendance
Pursuant to Virginia Code § 2.2-3707: Please take notice that members of the Powhatan County School Board may be present at the Strategic Plan Meeting to be held:
DATE: Wednesday, March 11, 2026
TIME: 9:00 AM to 12:00 PM
LOCATION: Pocahontas Landmark Center
4290 Anderson Hwy, Powhatan, VA
This notice is being provided in accordance with the Virginia Freedom of Information Act, as a quorum of school board members may be in attendance.
No official business will be conducted, and the School Board will make no votes or decisions at this event.
Pursuant to Virginia Code § 2.2-3707: Please take notice that members of the Powhatan County School Board may be present at the Strategic Plan Meeting to be held:
DATE: Wednesday, March 11, 2026
TIME: 9:00 AM to 12:00 PM
LOCATION: Pocahontas Landmark Center
4290 Anderson Hwy, Powhatan, VA
This notice is being provided in accordance with the Virginia Freedom of Information Act, as a quorum of school board members may be in attendance.
No official business will be conducted, and the School Board will make no votes or decisions at this event.

We had the pleasure of meeting Judy and Albert Conley Thursday morning as they were delivering Backpacks of Love bags to Pocahontas Elementary.
For those unfamiliar with the local nonprofit, Backpacks of Love was founded on the belief that no child should go hungry. Each week, volunteers provide bags of food for children to take home over the weekend. The nonprofit only served children in Powhatan when it was started in 2011, but it has expanded over the years to help children in nine localities.
As part of their weekly deliveries, the Conleys delivered 62 bags for children at Pocahontas Elementary, 32 for Powhatan Elementary, 38 for Flat Rock Elementary, and 16 for Powhatan Middle School. A big thank you to the Conleys, Backpacks of Love, and everyone who helps or contributes to the nonprofit to ensure no PCPS student goes hungry.
#WeArePCPS #TeamPowhatan
For those unfamiliar with the local nonprofit, Backpacks of Love was founded on the belief that no child should go hungry. Each week, volunteers provide bags of food for children to take home over the weekend. The nonprofit only served children in Powhatan when it was started in 2011, but it has expanded over the years to help children in nine localities.
As part of their weekly deliveries, the Conleys delivered 62 bags for children at Pocahontas Elementary, 32 for Powhatan Elementary, 38 for Flat Rock Elementary, and 16 for Powhatan Middle School. A big thank you to the Conleys, Backpacks of Love, and everyone who helps or contributes to the nonprofit to ensure no PCPS student goes hungry.
#WeArePCPS #TeamPowhatan

Mr. Powhatan 2026 is almost here! Powhatan High School will host a fabulous night of competition, talent, laughs, and fun as they crown the next Mr. Powhatan. The competition will be held on Friday, March 6 at 7 p.m. in the PHS Auditorium. Admission is $5, and all proceeds benefit the local Relay for Life chapter and the American Cancer Society. Cash payment accepted at the door or purchase tickets ahead of time on GoFan!
#WeArePCPS #TeamPowhatan
#WeArePCPS #TeamPowhatan

🚀 STEM EXPO is TONIGHT! 🔬⚙️🧪
In just a few hours, Powhatan High School will be buzzing with hands-on STEM fun from 5:00–7:00 p.m. – and you’re invited!
We have a record-breaking number of volunteers this year – over 200 student and teacher volunteers – ready to make this our most spectacular event yet. There will be amazing STEM exhibits and interactive activities showcasing the incredible STEM courses, clubs, and technologies available to Powhatan students. There will also be tons of door prizes throughout the evening, and the Cool Concessions Catering food truck will be on site selling dinner, with all proceeds supporting the Powhatan Education Foundation.
Bring the whole family and come explore, experiment, and discover. We can’t wait to see you tonight! 🧡🖤
#WeArePCPS #TeamPowhatan
In just a few hours, Powhatan High School will be buzzing with hands-on STEM fun from 5:00–7:00 p.m. – and you’re invited!
We have a record-breaking number of volunteers this year – over 200 student and teacher volunteers – ready to make this our most spectacular event yet. There will be amazing STEM exhibits and interactive activities showcasing the incredible STEM courses, clubs, and technologies available to Powhatan students. There will also be tons of door prizes throughout the evening, and the Cool Concessions Catering food truck will be on site selling dinner, with all proceeds supporting the Powhatan Education Foundation.
Bring the whole family and come explore, experiment, and discover. We can’t wait to see you tonight! 🧡🖤
#WeArePCPS #TeamPowhatan

Students Mr. Davis’s Algebra II class at Powhatan High School recently worked in groups to review polynomial operations and division through rotating stations. The lesson was designed by Ms. Angell, a senior at Longwood University who is completing her student teaching experience with Mr. Davis. She shared that engagement is a big focus for her, so the goal was to get students moving, talking, and collaborating with their group members while reinforcing key concepts. 🧡🖤
#WeArePCPS #TeamPowhatan
#WeArePCPS #TeamPowhatan






More than 175 Powhatan High School students recently had the opportunity to connect classroom learning to Virginia’s Civil Rights history.
During a Black History Month presentation, Leah Brown from the Robert Russa Moton Museum spoke about the 1951 Moton Student Strike, an effort led by 16-year-old Barbara Johns that contributed to the landmark Brown v. Board of Education decision.
At the end of the presentation, members of Rho Kappa National History Honor Society and the Diverse Hands at Work club surprised Ms. Brown with a $1,000 donation to support the museum. Students raised the funds through events including a Pie the Teacher fundraiser, bake sales, a cookout, and this weekend’s dodgeball tournament. We are so proud of our students for their hard work and generosity. 🧡🖤
#WeArePCPS #TeamPowhatan
During a Black History Month presentation, Leah Brown from the Robert Russa Moton Museum spoke about the 1951 Moton Student Strike, an effort led by 16-year-old Barbara Johns that contributed to the landmark Brown v. Board of Education decision.
At the end of the presentation, members of Rho Kappa National History Honor Society and the Diverse Hands at Work club surprised Ms. Brown with a $1,000 donation to support the museum. Students raised the funds through events including a Pie the Teacher fundraiser, bake sales, a cookout, and this weekend’s dodgeball tournament. We are so proud of our students for their hard work and generosity. 🧡🖤
#WeArePCPS #TeamPowhatan










Powhatan County Public Schools will open on a two-hour delay on Monday, February 23, 2026. Overnight snowfall has created slick parking lot and sidewalk conditions at the schools. The delay will allow additional time for school campus preparation to ensure safe travel for students and staff. Thank you for your patience and partnership as we prioritize safety.

